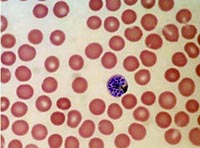

Đầu năm 2007, một số tạp chí y học khá nổi tiếng đăng tải hơn 10 trường hợp về các ca sốt rét nặng và ác tính do ký sinh trùng sốt rét P.vivax gây ra (vốn trước đây P.vivax hiếm hoặc không gây sốt rét nặng và ác tính). Nhân đây, chúng tôi lược dịch báo cáo 2 bệnh nhi sốt rét do Plasmodium vivax, cả hai đều 12 tuổi, bị biến chứng động kinh, co giật và có triệu chứng về bệnh lý não màng não lan tỏa (diffuse meningoencephalitis). Một bệnh nhi có biểu hiện các dấu hiệu về màng não điển hình, trong khi ca còn lại có biểu hiện bệnh lý tại não. Cả hai trường hợp được điều trị bằng artesunate. Thực tế, hiếm khi thấy trong quá trình nhiễm Plasmodium vivax lại xuất hiện biến chứng nặng và các triệu chứng thể não như thế.
Sốt rét ác tính thể não thường xảy ra trên các bệnh nhân nhiễm Plasmodium falciparum. Tuy nhiên, đã có những báo cáo về sốt rét ác tính thể não liên quan đến Plasmodium vivax. Với thông tin và kiến thức và chúng tôi có chỉ 45 ca sốt rét do P.vivax gây biểu hiện bệnh lý ở hệ thần kinh trung ươngđược báo cáo trong y văn Anh từ năm 1920 và khoảng một nửa số ca này xảy ra trên bệnh nhi.
Báo cáo 2 ca bệnh
Hai bệnh nhi nam, tuổi cùng là 12 có biểu hiện sốt cao từng cơn trong thời gian hơn 4 ngày. Cả hai ca đều thay đổi ý thức kể từ khi nhập viện. Hai bệnh nhi đều có tiền sử co giật kiểu giật cơ toàn thân (generalized tonic clonic convulsion) trước khi nhập viện. Cả hai đều mất nước trầm trọng. xét nghiệm đường huyết mao mạch của trẻ bình thường. Ngoài các dấu hiệu này, một số đặc điểm để phân biệt giữa 2 ca bệnh khác nhau.
Đặc điểm khác biệt giữa hai bệnh nhi sốt rét ác tính thể não
| Đặc điểm BN | Trường hợp 1 | Trường hợp 2 |
1 | Triệu chứng LS | 1.Thể trạng và ý thức thay đổi trong 24 giờ qua. 2.Co giật toàn thân 3.Bí tiểu 4.Hồi phục sau 10 giờ | 1.Không có ý thức tại thời điểm nhập viện. 2.Co giật toàn thân. 3.Hồi phục sau 15 giờ |
2 | Khám lâm sàng | 1.Thang điểm Glasgow, EMV-11 điểm 2.Dấu chứng màng não 3.Dãn cơ hai bên thân 4.Đồng tử bình thường 5.Lách to, 6cm dưới bờ sườn có thể sờ chạm | 1.Thang điểm Glasgow, EMV-5 điểm 2.Dãn cơ hai bên thân 3.Đồng tử dãn nhẹ 4.Không có gan lách lớn |
3 | Kết quả XN | 1.Hemoglobine 6g% 2.Các thông số thận bình thường | 1.Hemoglobine 13.7g% 2.Urea và Creatinine tăng. |
Trên hai ca bệnh nhi đều được chỉ định xét nghiẹm công thức máu, kiểm tra chức năng gan và điện giải đồ đều cho kết quả trong giới hạn bình thường. Lam máu ngoại vi cho thấy nhiều thể tư dưỡng của P.vivax; xét nghiệm bằng test chẩn đoán nhanh OptiMAL cho két quả dương tính với P.vivax trong khi cả hai đều âm tính với P.falciparum. Xét nghiệm dịch não tủy và làm điện não đồ (EEG) thì kết quả bình thường. Tiến hành điều trị triệu chứng và điều trị đặc hiệu bằng artesunate bằng đường truyền tĩnh mạch theo liều khuyến cáo. Sau 2 ngày điều trị, kiểm tra lam máu cho thấy sạch ký sinh trùng. Cả hai bệnh nhi được cho xuất viện trong tình trạng lâm sàng ổn định và tiếp tục dùng primaquine thêm 14 ngày nữa. Tiếp tục theo dõi bênh nhân 1 tháng cho thấy không có di chứng nào về thần kinh. |
| Plasmodium vivax |
Bàn luận:
Các đặc điểm gây tổn thương đa cơ quan như trong sốt rét nặng và ác tính do P.falciparum thì ở đây P.vivax lại không thường gặp.Bất kỳ bệnh nhân nào nhiễm P.vivax mà có biều hiện sốt rét nặng thì coi như là bênh nhân đó có lẽ nhiễm phối hợp (P.f và P.v). Tuy nhiên, điều đó không phải luôn luôn đúng. Vì bằng chứng cụ thể từ báo cáo ở đây chỉ có nhiễm P.vivax và gây sốt rét ác tính thể não (xét nghiệm giêm sa và test chẩn đoán nhanh đều âm tính với P.faciparum). Các dữ liệu lâm sàng được Kochar và cộng sự cung cấp đã chỉ rằng P. vivax có thể gây ra các biến chứng có liên quan đến sự ẩn cư hoặc không ẩn cư (sequestration) của một sốt rét ác tính thể não mà chúng ta thường gặp trong bệnh nhân nhiễm P.falciparum. Tuy nhiên cơ chế bệnh sinh của nó vẫn chưa được hiểu thấu đáo.Sachdev và Mohan đã nghiên cứu hồ sơ xét nghiệm lâm sàng (clinicolaboratory profile) của 6 bệnh nhân bị sốt rét ác tính thể não do P.vivax. Các đặc điểm hiện có là của motọ bệnh lý não cấp do sốt cao gồm co giật và hôn mê. Cacs dấu hiệu thần kinh khu trú được quan sát trên một bệnh nhân. Gần đây, Ozen và cộng sự đã mô tả một trường hợp sốt rét ác tính thể não do P.vivax cho thấy có trạng thái động kinh. Một vài chuyên gia cũng đưa ra ý tưởng rằng phải chăng các bệnh nhân sốt rét ác tính thể não có thể có một rối loạn hoặc bệnh lý động kinh có sẵn (underlying seizure disorder) và những cơn động kinh như thế đã tạm lằng một thời gian nay lại được kích thích trở lại do sốt cao chăng?
of EID at www.cdc.gov/eid